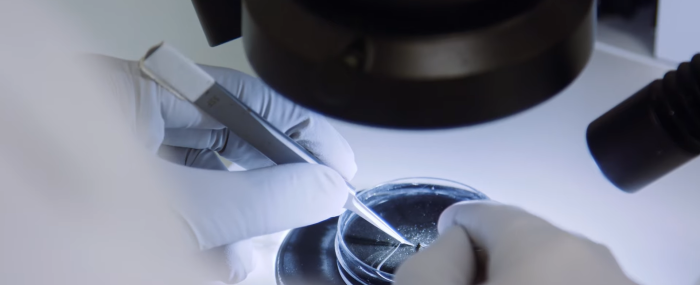
Appels à projets recherche clinique 2026

Faire une nouvelle recherche
Faire une nouvelle recherche
Résultat de la recherche
Mapping of Clinical Trials in Hearing Disorders
Découvrir l'articlePolitique de confidentialité - Höra
Découvrir l'articleLe Centre National d'Information sur les Surdités (CNIS) se conjugue dorénavant au pluriel et lance une nouvelle version de son site internet "Surdités Info Service"
Le Centre National d'Information sur les Surdités (CNIS) se conjugue dorénavant au pluriel et lance une nouvelle version de son site internet "Surdités Info Service"
374Ko
pdf
Fichier
CP FPA x CNISVF. docx.pdf